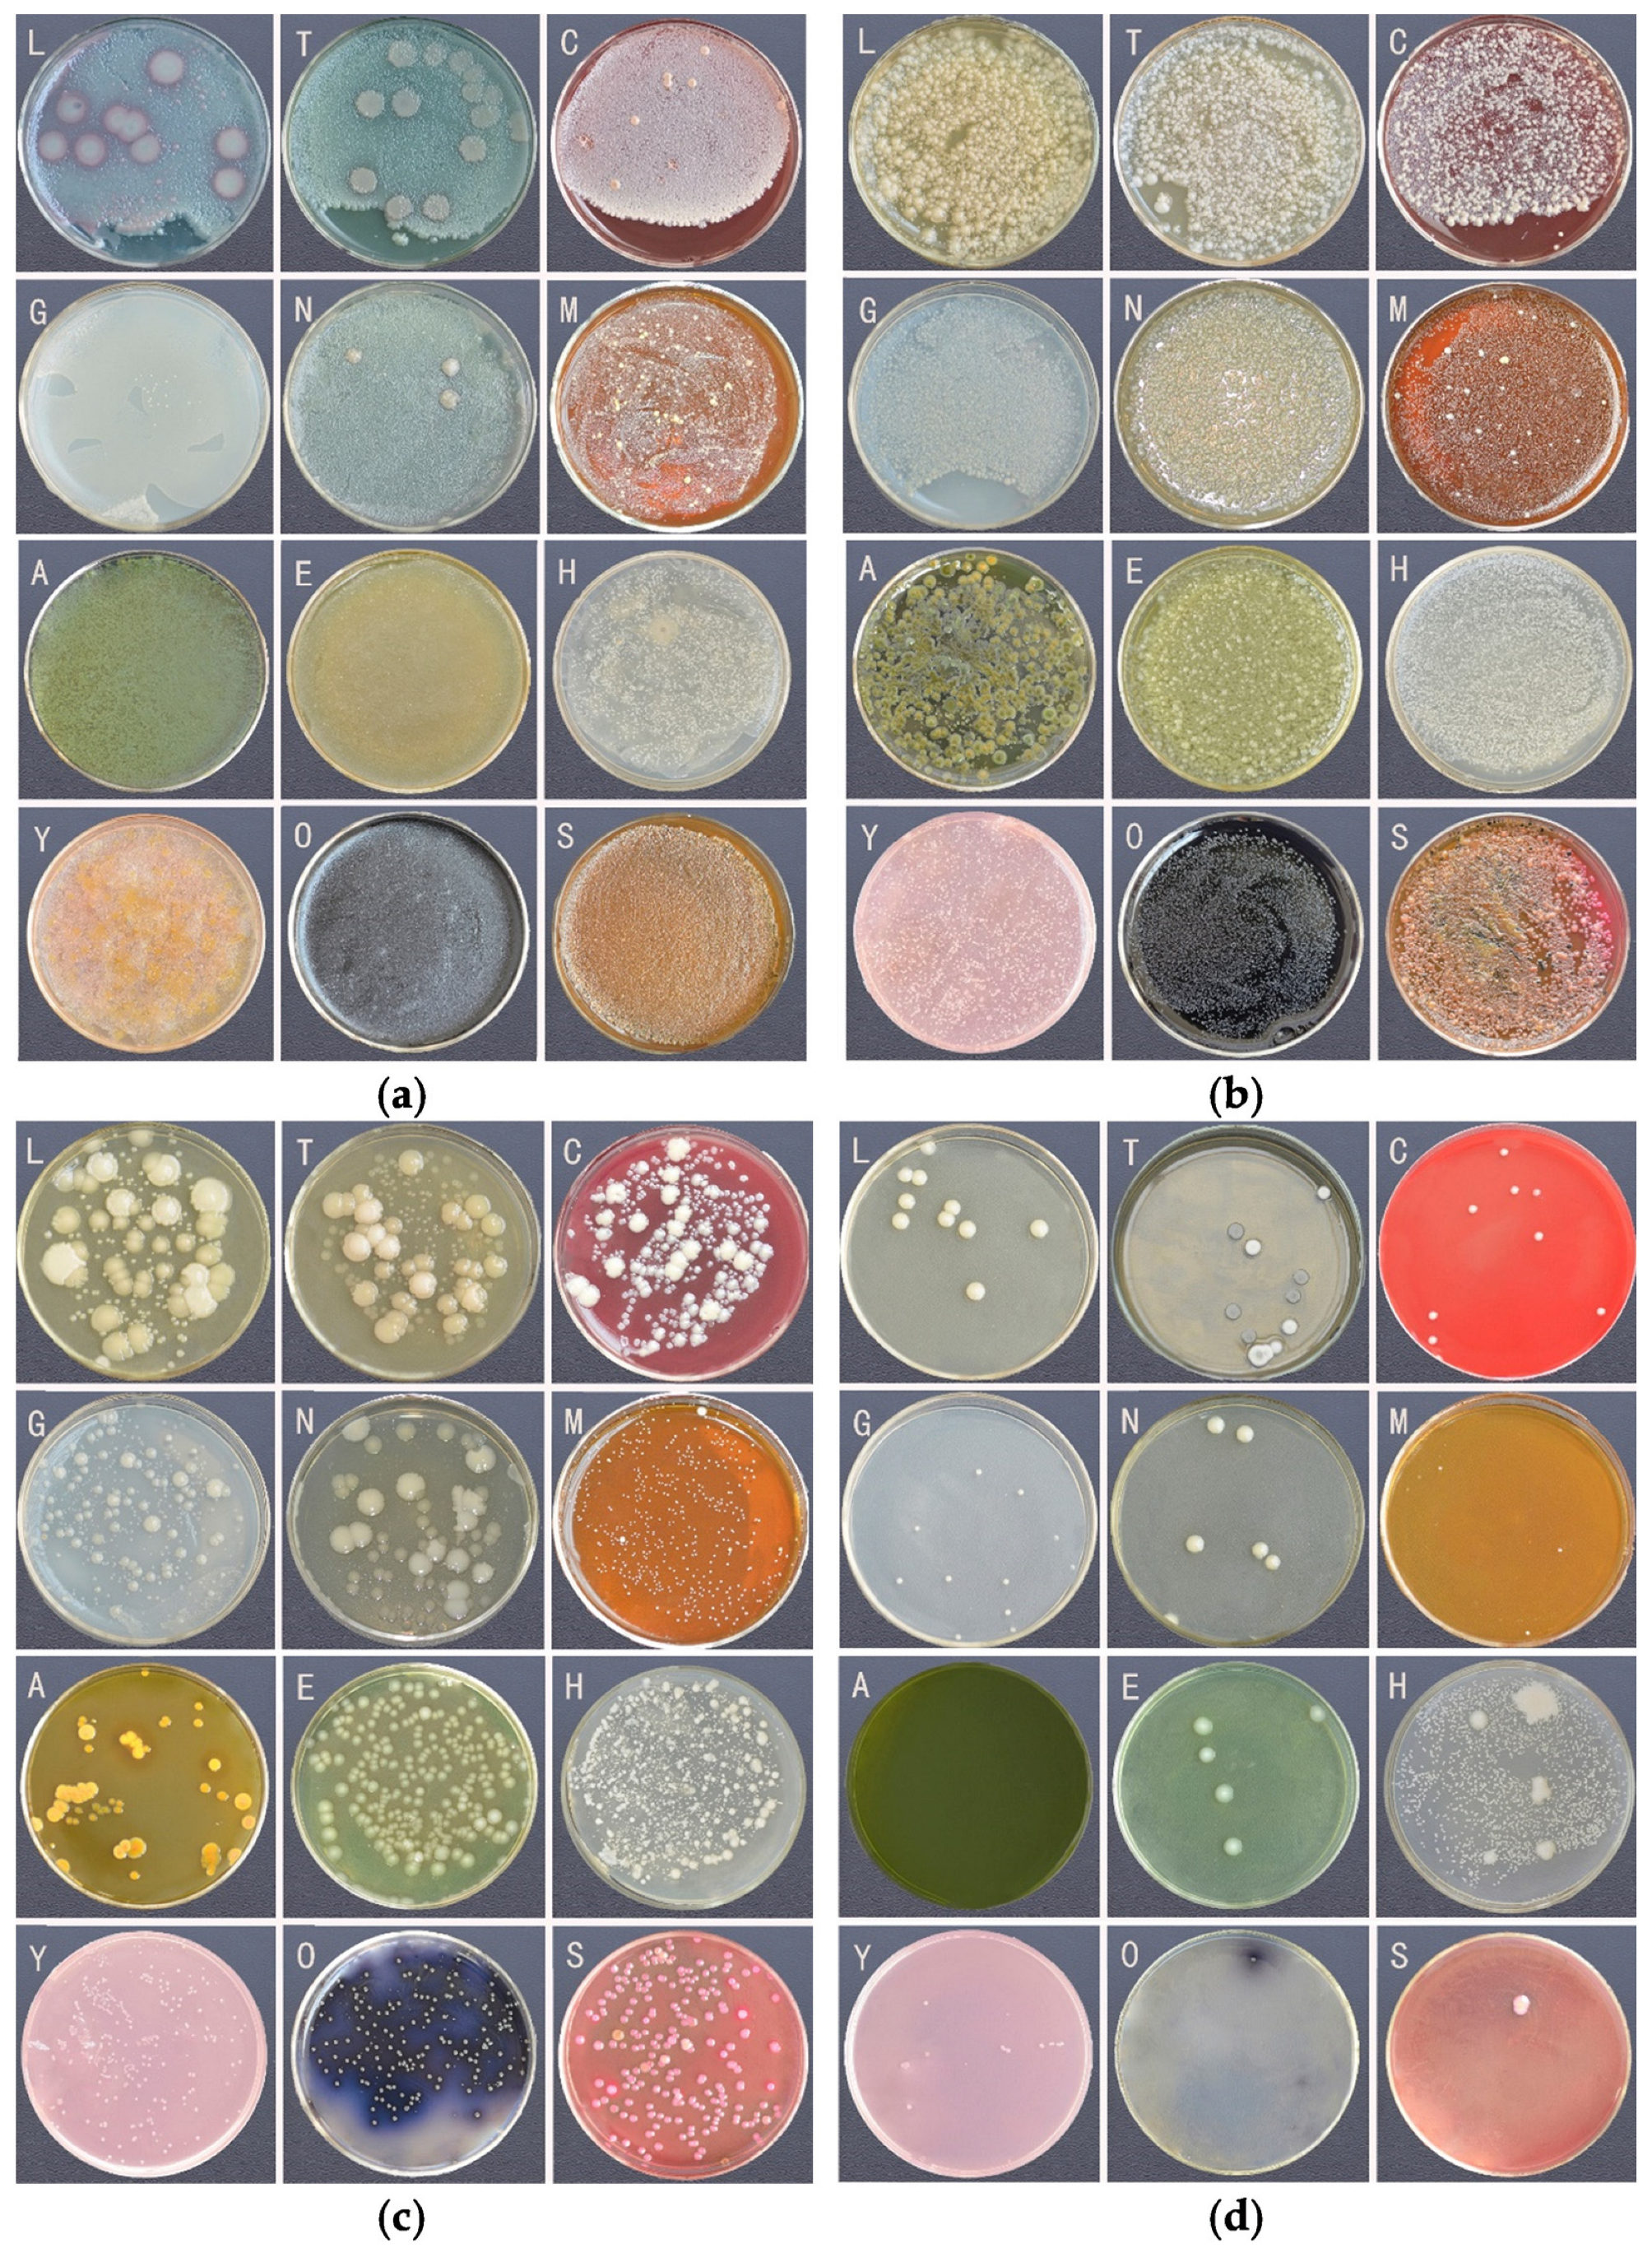
Insects 16 00123 g001

The Gut Bacteria of Gampsocleis gratiosa (Orthoptera: Tettigoniidae) by Culturomics
Simple Summary
Abstract
1. Introduction
2. Materials and Methods
2.1. Samples
2.2. Culturomics
2.2.1. Gradient Culture of Bacterial Suspension
2.2.2. Isolation and Purification of Single Colonies
2.2.3. Species Identification
2.2.4. Study on the Morphological Characteristics of the Gut Bacterial
2.2.5. Physiological and Biochemical Properties
3. Results
3.1. Bacterial Diversity of the Gut Bacteria Using Culturomics
3.2. The Effect of Culture Conditions on Bacterial Culture
3.3. Morphological and Physiological and Biochemical Characteristics of Strains
3.3.1. Physiological and Biochemical Characteristics
3.3.2. pH Gradient Culture Test
3.3.3. Drug Susceptibility Testing
4. Discussion
5. Conclusions
Supplementary Materials
Author Contributions
Funding
Data Availability Statement
Conflicts of Interest
References
- Kashima, T.; Nakamura, T.; Tojo, S. Uric acid recycling in the shield bug, Parastrachia japonensis (Hemiptera: Parastrachiidae), during diapause. J. Insect Physiol. 2006, 52, 816–825. [Google Scholar] [CrossRef] [PubMed]
- Pernice, M.; Simpson, S.J.; Ponton, F. Towards an integrated understanding of gut microbiota using insects as model systems. J. Insect Physiol. 2014, 69, 12–18. [Google Scholar] [CrossRef]
- Erkosar, B.; Storelli, G.; Defaye, A.; Leulier, F. Host-intestinal microbiota mutualism: “learning on the fly”. Cell Host Microbe 2013, 13, 8–14. [Google Scholar] [CrossRef] [PubMed]
- Allegrucci, G.; Sbordoni, V. Insights into the molecular phylogeny of Rhaphidophoridae, an ancient, worldwide lineage of Orthoptera. Mol. Phylogenetics Evol. 2019, 138, 126–138. [Google Scholar] [CrossRef] [PubMed]
- Zhou, Z.; Kou, X.; Qian, L.; Liu, J. Transcriptome profile of Chinese bush cricket, Gampsocleis gratiosa: A resource for microsatellite marker development. Entomol. Res. 2016, 46, 197–205. [Google Scholar] [CrossRef]
- Zhou, Z.; Shi, F.; Huang, Y. The complete mitogenome of the Chinese bush cricket, Gampsocleis gratiosa (Orthoptera: Tettigonioidea). J. Genet. Genom. 2008, 35, 341–348. [Google Scholar] [CrossRef] [PubMed]
- Su, C.; Chen, J.; Shi, F.; Guo, M.; Chang, Y. Formation of the acrosome complex in the bush cricket Gampsocleis gratiosa (Orthoptera: Tettigoniidae). Arthropod Struct. Dev. 2017, 46, 579–587. [Google Scholar] [CrossRef] [PubMed]
- Zhou, Z.; Huang, H.; Che, X. Bacterial communities in the feces of laboratory reared Gampsocleis gratiosa (Orthoptera: Tettigoniidae) across different developmental stages and sexes. Insects 2022, 13, 361. [Google Scholar] [CrossRef] [PubMed]
- Xu, L.; Sun, L.; Zhang, S.; Wang, S.; Lu, M. High-resolution profiling of gut bacterial communities in an invasive beetle using PacBio SMRT sequencing system. Insects 2019, 10, 248. [Google Scholar] [CrossRef]
- Meng, Y.; Li, S.; Zhang, C.; Zheng, H. Strain-level profiling with picodroplet microfluidic cultivation reveals host-specific adaption of honeybee gut symbionts. Microbiome 2022, 10, 140. [Google Scholar] [CrossRef] [PubMed]
- Xu, J.; Sun, L.; Xing, X.; Sun, Z.; Gu, H.; Lu, X.; Li, Z.; Ren, Q. Culturing bacteria from fermentation pit muds of Baijiu with culturomics and amplicon-based metagenomic approaches. Front. Microbiol. 2020, 11, 1223. [Google Scholar] [CrossRef]
- Lagier, J.C.; Armougom, F.; Million, M.; Hugon, P.; Pagnier, I.; Robert, C. Microbial culturomics: Paradigm shift in the human gut microbiome study. Clin. Microbiol. Infect. 2012, 18, 1185–1193. [Google Scholar] [CrossRef] [PubMed]
- Lagier, J.C.; Khelaifia, S.; Alou, M.T.; Ndongo, S.; Dione, N.; Hugon, P. Culture of previously uncultured members of the human gut microbiota by culturomics. Nat. Microbiol. 2016, 1, 16203. [Google Scholar] [CrossRef] [PubMed]
- Prabhakar, C.S.; Sood, P.; Kanwar, S.S.; Sharma, P.N.; Kumar, A.; Mehta, P.K. Isolation and characterization of gut bacteria of fruit fly, Bactrocera tau (Walker). Phytopharmaceutica 2013, 41, 193–201. [Google Scholar] [CrossRef]
- Campillo, T.; Luna, E.; Portier, P.; Fischer-Le Saux, M.; Lapitan, N.; Tisserat, N.A.; Leach, J.E. Erwinia iniecta sp. nov., isolated from Russian wheat aphid (Diuraphis noxia). Int. J. Syst. Evol. Microbiol. 2015, 65, 3625–3633. [Google Scholar] [CrossRef] [PubMed]
- Zhang, S.; Huang, J.; Wang, Q.; You, M.; Xia, X. Changes in the host gut microbiota during parasitization by parasitic wasp Cotesia vestalis. Insects 2022, 13, 760. [Google Scholar] [CrossRef]
- Smith, C.C.; Srygley, R.B.; Healy, F.; Swaminath, K.; Mueller, U.G. Spatial structure of the Mormon cricket gut microbiome and its predicted contribution to nutrition and immune function. Front. Microbiol. 2017, 8, 801. [Google Scholar] [CrossRef] [PubMed]
- Zheng, X.; Zhu, Q.; Zhou, Z.; Wu, F.; Chen, L.; Cao, Q.; Shi, F. Gut bacterial communities across 12 Ensifera (Orthoptera) at different feeding habits and its prediction for the insect with contrasting feeding habits. PLoS ONE 2021, 16, e0250675. [Google Scholar] [CrossRef]
- Zheng, X.; Zhu, Q.; Qin, M.; Zhou, Z.; Liu, C.; Wang, L.; Shi, F. The role of feeding characteristics in shaping gut microbiota composition and function of Ensifera (Orthoptera). Insects 2022, 13, 719. [Google Scholar] [CrossRef] [PubMed]
- Lagier, J.C.; Dubourg, G.; Million, M.; Cadoret, F.; Bilen, M.; Fenollar, F.; Levasseur, A.; Rolain, J.M.; Fournier, P.E.; Raoult, D. Culturing the human microbiota and culturomics. Nat. Rev. Microbiol. 2018, 16, 540–550. [Google Scholar] [CrossRef]
- Oberhardt, M.A.; Zarecki, R.; Gronow, S.; Lang, E.; Klenk, H.; Gophna, U.; Ruppin, E. Harnessing the landscape of microbial culture media to predict new organism-media pairings. Nat. Commun. 2015, 6, 8493. [Google Scholar] [CrossRef]
- Weisburg, W.G.; Barns, S.M.; Pelletier, D.A.; Lane, D.J. 16S ribosomal DNA amplification for phylogenetic study. J. Bacteriol. 1991, 173, 697–703. [Google Scholar] [CrossRef] [PubMed]
- Dong, X.; Zhou, Y.; Zhu, H. Manual for Systematic Classification and Identification of Common Bacteria and Archaea, 1st ed.; Science Press: Beijing, China, 2023; pp. 510–544. [Google Scholar]
- Augustinos, A.A.; Tsiamis, G.; Caceres, C.; Abd-Alla, A.M.M.; Bourtzis, K. Taxonomy, diet, and developmental stage contribute to the structuring of gut-associated bacterial communities in tephritid pest species. Front. Microbiol. 2019, 10, 2004. [Google Scholar] [CrossRef] [PubMed]
- Osei-Poku, J.; Mbogo, C.M.; Palmer, W.J.; Jiggins, F.M. Deep sequencing reveals extensive variation in the gut microbiota of wild mosquitoes from Kenya. Mol. Ecol. 2012, 21, 5138–5150. [Google Scholar] [CrossRef] [PubMed]
- Engel, P.; Moran, N.A. The gut microbiota of insects—Diversity in structure and function. FEMS Microbiol. Rev. 2013, 37, 699–735. [Google Scholar] [CrossRef] [PubMed]
- Muratore, M.; Prather, C.; Sun, Y. The gut bacterial communities across six grasshopper species from a coastal tallgrass prairie. PLoS ONE 2020, 15, e0228406. [Google Scholar] [CrossRef]
- De Filippo, C.; Cavalieri, D.; Di Paola, M.; Ramazzotti, M.; Poullet, J.B.; Massart, S.; Collini, S.; Pieraccini, G.; Lionetti, P. Impact of diet in shaping gut microbiota revealed by a comparative study in children from Europe and rural Africa. Proc. Natl. Acad. Sci. USA 2010, 107, 14691–14696. [Google Scholar] [CrossRef] [PubMed]
- Redford, A.J.; Fierer, N. Bacterial succession on the leaf surface: A novel system for studying successional dynamics. Microbiol. Ecol. 2009, 58, 189–198. [Google Scholar] [CrossRef] [PubMed]
- Teeling, H.; Fuchs, B.M.; Becher, D.; Klockow, C.; Gardebrecht, A.; Bennke, C.M.; Kassabgy, M.; Huang, S.; Mann, A.J.; Waldmann, J.; et al. Substrate-controlled succession of marine bacterioplankton populations induced by a phytoplankton bloom. Science 2012, 336, 608–611. [Google Scholar] [CrossRef] [PubMed]
- Pascault, N.; Roux, S.; Artigas, J.; Pesce, S.; Leloup, J.; Tadonleke, R.D.; Debroas, D.; Bouchez, A.; Humbert, J.F. A high-throughput sequencing ecotoxicology study of freshwater bacterial communities and their responses to tebuconazole. FEMS Microbiol. Ecol. 2014, 90, 563–574. [Google Scholar] [CrossRef]
- Whon, T.W.; Kim, M.S.; Roh, S.W.; Shin, N.R.; Lee, H.W.; Bae, J.W. Metagenomic characterization of airborne viral DNA diversity in the near-surface atmosphere. J. Virol. 2012, 86, 8221–8231. [Google Scholar] [CrossRef] [PubMed]
- Lagier, J.C.; Hugon, P.; Khelaifia, S.; Fournier, P.E.; La Scola, B.; Raoult, D. The rebirth of culture in microbiology through the example of culturomics to study human gut microbiota. Clin. Microbiol. Rev. 2015, 28, 237–264. [Google Scholar] [CrossRef] [PubMed]
- Watanabe, H.; Tokuda, G. Cellulolytic systems in insects. Annu. Rev. Entomol. 2010, 55, 609–632. [Google Scholar] [CrossRef]
- Demirci, M.; Sevim, E.; Demir, I.; Sevim, A. Culturable bacterial microbiota of Plagiodera versicolora (L.) (Coleoptera: Chrysomelidae) and virulence of the isolated strains. Folia Microbiol. 2013, 58, 201–210. [Google Scholar] [CrossRef]
- Yadav, D.S.; Ranade, Y.; Sawant, I.; Ghule, S.; Mhaske, S. Isolation, identification and functional characterisation of bacteria associated with gut of wood feeding Stromatium barbatum (Fabr.) (Coleoptera: Cerambycidae) larvae. Int. J. Trop. Insect Sci. 2022, 42, 2603–2616. [Google Scholar] [CrossRef]
- Mustafa, G.; Zahid, M.T.; Ali, S.; Abbas, S.Z.; Rafatullah, M. Biodegradation and discoloration of disperse blue-284 textile dye by Klebsiella pneumoniae GM-04 bacterial isolate. J. King Saud Univ. Sci. 2021, 33, 101442. [Google Scholar] [CrossRef]
- Nelson, K.; Muge, E.; Wamalwa, B. Cellulolytic Bacillus species isolated from the gut of the desert locust Schistocerca gregaria. Sci. Afr. 2021, 11, e00665. [Google Scholar] [CrossRef]
- Acar, J.F. Classification of antibiotics. Rev. Prat. 1977, 27, 2757–2759. [Google Scholar] [PubMed]
- Robinson, C.J.; Schloss, P.; Ramos, Y.; Raffa, K.; Handelsman, J. Robustness of the bacterial community in the cabbage white butterfly larval midgut. Microb. Ecol. 2010, 59, 199–211. [Google Scholar] [CrossRef] [PubMed]
- Culp, E.J.; Waglechner, N.; Wang, W.; Fiebig-Comyn, A.A.; Hsu, Y.P.; Koteva, K.; Sychantha, D.; Coombes, B.K.; Van Nieuwenhze, M.S.; Brun, Y.V.; et al. Evolution-guided discovery of antibiot-ics that inhibit peptidoglycan remodelling. Nature 2020, 578, 582–587. [Google Scholar] [CrossRef] [PubMed]
- Kapoor, G.; Saigal, S.; Elongavan, A. Action and resistance mechanisms of antibiotics: A guide for clinicians. J. Anaesthesiol. Clin. Pharmacol. 2017, 33, 300–305. [Google Scholar] [CrossRef] [PubMed]
- Kim, J.; Ahn, J. Emergence and spread of antibiotic-resistant foodborne pathogens from farm to table. Food Sci. Biotechnol. 2022, 31, 1481–1499. [Google Scholar] [CrossRef] [PubMed]

| No. | Medium | Abbreviate |
|---|---|---|
| 1 | LB Agar solid medium | LB |
| 2 | Tryptic Soy Agar | TSA |
| 3 | MRS medium | MRS |
| 4 | Gauze’s Medium No.1, Modified | GAO |
| 5 | Nutrient Agar Medium | NAM |
| 6 | Columbia Blood Agar | BLA |
| 7 | Aeromonas Medium | AER |
| 8 | Enterococcus Agar | ENT |
| 9 | Enterobacteria Enrichment Broth | EE |
| 10 | Salmonella-Shigella Agar | SS |
| 11 | Carrot Agar | CAR |
| 12 | YCFA Medium | YCFA |
Disclaimer/Publisher’s Note: The statements, opinions and data contained in all publications are solely those of the individual author(s) and contributor(s) and not of MDPI and/or the editor(s). MDPI and/or the editor(s) disclaim responsibility for any injury to people or property resulting from any ideas, methods, instructions or products referred to in the content. |
© 2025 by the authors. Licensee MDPI, Basel, Switzerland. This article is an open access article distributed under the terms and conditions of the Creative Commons Attribution (CC BY) license (https://creativecommons.org/licenses/by/4.0/).
Share and Cite
Li, H.; Huang, H.; Jia, Y.; Tong, Y.; Zhou, Z. The Gut Bacteria of Gampsocleis gratiosa (Orthoptera: Tettigoniidae) by Culturomics. Insects 2025, 16, 123. https://doi.org/10.3390/insects16020123
Li H, Huang H, Jia Y, Tong Y, Zhou Z. The Gut Bacteria of Gampsocleis gratiosa (Orthoptera: Tettigoniidae) by Culturomics. Insects. 2025; 16(2):123. https://doi.org/10.3390/insects16020123
Chicago/Turabian StyleLi, Hongmei, Huimin Huang, Ying Jia, Yuwei Tong, and Zhijun Zhou. 2025. "The Gut Bacteria of Gampsocleis gratiosa (Orthoptera: Tettigoniidae) by Culturomics" Insects 16, no. 2: 123. https://doi.org/10.3390/insects16020123
APA StyleLi, H., Huang, H., Jia, Y., Tong, Y., & Zhou, Z. (2025). The Gut Bacteria of Gampsocleis gratiosa (Orthoptera: Tettigoniidae) by Culturomics. Insects, 16(2), 123. https://doi.org/10.3390/insects16020123






